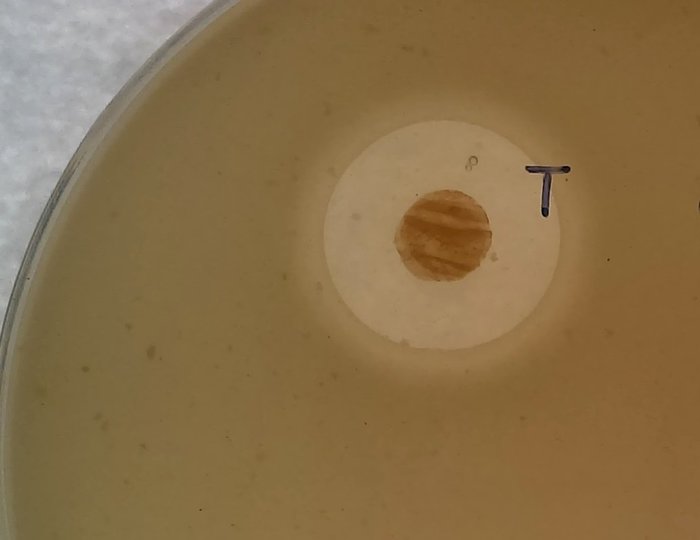

Гаджет-пластырь от супербактерий
Бесконтрольный доступ к антибиотикам породил глобальную проблему для человечества, которая грозит отбросить медицину в эпоху средневековья. Все дело в том, что «недолеченные» пациенты становятся идеальной базой для созревания супербактерий. Бактерий, устойчивых к последующим порциям антибиотиков и заражающих все подряд. И спасения от них нет. По крайней мере, не наблюдалось в ближайшей перспективе.
Суть инновации в борьбе с супербактериями
Поскольку все больше бактерий, вызывающих заболевания, становятся все более устойчивыми к антибиотикам, человечеству нужны принципиально другие способы борьбы. Одно из решений кроется в электрических разрядах, правильная подача которых мешает бактериям проникать через нашу кожу.
Прорыв совершили исследователи из Чикагского университета и Калифорнийского университета в Сан-Диего. В статье, опубликованной в журнале Device на этой неделе, команда подробно описала, как устройство снижает активность вредоносных генов в инфекционных бактериях и сдерживает рост популяций.
Исследование было успешно проведено с использованием бактерии Staphylococcus epidermidis на коже свиньи. Это типичный разносчик «больничных инфекций», бактерия, которая размножается именно в больницах, приобретая устойчивость к широкому спектру антисептиков. Поэтому, если новое решение безопасно для человека и воздействует на различные типы бактериальных инфекций, то это буквально мини-революция в области медицины.
Более того, роль бактерий и микробиома в целом – опасно недооценивать. Наш образ жизни и питание напрямую могут влиять на то, как микрофлора кишечника провоцирует развитие депрессии.
Принцип борьбы с супербактериями
В ходе исследования ученые обнаружили, что некоторые бактерии были «избирательны» в отношении среды, в которой они проявляют возбудимость. То есть, поведение бактерий зависело от того, какая атмосфера царила вокруг них. В частности, Staphylococcus epidermidis становятся возбудимыми под здоровой кожей, которая представляет собой кислую среду.
Вооружившись этими знаниями, ученые приступили к практическому изучению потенциала технологии, используя кожу свиней, гидрогель для воссоздания кислой среды и гибкий пластырь. Сам процесс получил название как: Биоэлектронная Локализованная Антимикробная Стимулирующая ТЕРапия, или — БЛАСТЕР.
В этом исследовании биоэлектронный пластырь был прикреплен к свиной коже вместе с гидрогелем, который поддерживал кислую среду для возбудимости бактерий. Чикагский университет/Калифорнийский университет в Сан-Диего
Принцип лечения прост: подача слабого электрического сигнала в 1,5 вольта — намного ниже безопасного предела в 15 вольт для человека — в течение 10 секунд каждые 10 минут в течение 18 часов через пластырь. Это остановило 99% скоплений бактерий, которые образуются для блокировки лекарств и вызывают инфекции. Также на обработанном образце кожи было почти в 10 раз меньше S. epidermidis по сравнению с необработанным образцом коже после 18-часового цикла.
Перспективы технологии
Это может стать большой победой в лечении инфекций еще по нескольким причинам. Помимо работы с бактериями, устойчивыми к антибиотикам, технология может свести на нет необходимость в антибиотиках для обычных видов инфекций. Технологию можно использовать в отдаленных районах, куда сложно доставлять лекарства на регулярной основе. Кроме того, небольшой пластырь позволяет проводить целенаправленное лечение на небольшом участке кожи, что снижает вероятность потенциальных побочных эффектов. Как и следовало ожидать, в этой области предстоит еще много работы.
Открытие этой избирательной возбудимости поможет нам узнать, как контролировать другие виды бактерий, рассматривая различные условия.
Соавтор, Сэхён Ким из Чикагского университета.
Старший соавтор Божи Тянь, также из Чикагского университета, объяснил, что есть возможность разработать пластырь с беспроводной цепью для контроля инфекций без лекарств, а также дополнительно оценить эффективность подобного лечения.
По данным Всемирной организации здравоохранения, устойчивость бактерий к антибиотикам стала прямой причиной 1,27 миллиона смертей во всем мире в 2019 году. Данное лечение может потенциально помочь предотвратить серьезные заболевания, вызванные бактериями, устойчивыми к антибиотикам, и спасти жизни.
Больше материалов про тонкую грань между наукой и потенциалом человечества, про наше сознание, мозг и перспективы слияния с технологиями, или про расширение возможностей тела и разума – читайте в материалах сообщества. Подписывайтесь, чтобы не пропустить свежие статьи!